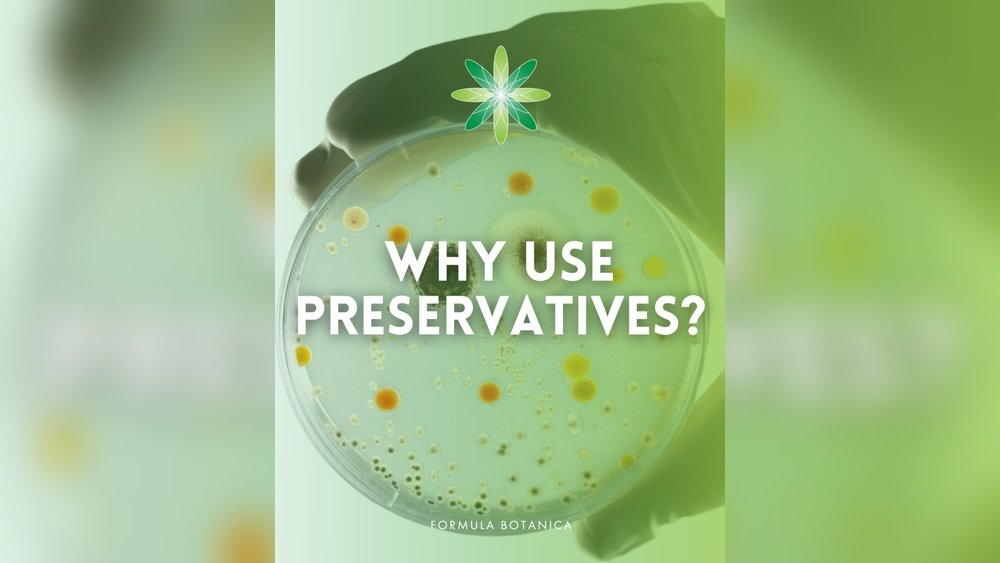
Which Cosmetic Preservatives are Mild

Which Cosmetic Preservatives are Mild: Safe Choices for Sensitive Skin
When you choose cosmetics, you want products that are not only effective but also gentle on your skin. Preservatives play a crucial role in keeping these products safe and fresh, but not all preservatives are created equal.
Some can cause irritation or allergic reactions, especially if you have sensitive skin. So, which cosmetic preservatives are mild enough to protect your products without compromising your skin’s health? You’ll discover the safest and gentlest preservatives commonly used in cosmetics today.
You’ll learn how they work, why they’re considered mild, and how to spot them on ingredient labels. Keep reading to find out how to protect your skin and your favorite products at the same time.

Credit: www.amazon.com
Safe Preservative Types
Choosing safe preservatives is important for mild cosmetic products. These preservatives help stop bacteria, yeast, and mold growth. They keep products fresh and safe for skin use.
Safe preservatives often come from natural sources or are nature-identical synthetics. These options reduce the risk of irritation and allergic reactions.
Nature-identical synthetics are lab-made but mimic natural compounds. They offer reliable protection without harsh effects. These preservatives balance safety and effectiveness.
Natural Preservative Systems
Natural preservative systems use blends of plant-based ingredients. They work together to fight bacteria, fungi, and yeast. These systems suit formulas aiming for a natural label.
Preservative Eco (geogard Ect)
Preservative Eco is a popular ECOCERT-approved blend. It contains benzyl alcohol, salicylic acid, glycerin, and sorbic acid. This blend is gentle yet effective in many cosmetic products.
Sodium Benzoate And Potassium Sorbate
This preservative pair works well in acidic products. They protect against bacteria and fungi broadly. Both ingredients are mild and approved for natural cosmetics.
Benzyl Alcohol
Benzyl alcohol is found in some essential oils. It provides broad protection and is generally safe. It also acts as a solvent and fragrance enhancer.
Phenoxyethanol
Phenoxyethanol is a synthetic preservative often used instead of parabens. It protects against a wide range of microbes. This ingredient is well tolerated on most skin types.
Fermentation-based Preservatives
Fermentation-based preservatives like Leucidal Liquid come from natural fermentation. They use probiotics to fight microbes gently. These are growing in popularity for natural skincare.
Key Considerations For Safe Preservatives
Broad-spectrum activity matters. Many preservatives protect only specific microbes. Combining preservatives often ensures full protection.
Check the pH level. Some preservatives need acidic conditions to work best. Adjust your formula accordingly.
Consider formulation needs. Water content and other ingredients affect preservative choice. Pick the one that fits your product well.
Organic standards may limit preservative options. Choose those approved for organic certification if needed.

Credit: www.cosmeticsnow.com
Popular Mild Preservatives
Popular mild preservatives are essential for safe cosmetic products. They prevent harmful bacteria, mold, and yeast from growing. These preservatives protect both the product and the user without harsh effects. Mild preservatives suit sensitive skin and natural formulations. Below are some widely used mild preservatives in cosmetics.
Sodium Benzoate And Potassium Sorbate
Sodium Benzoate and Potassium Sorbate work well in acidic products. They prevent the growth of bacteria and fungi effectively. These preservatives are common in creams, lotions, and shampoos. They are gentle on the skin and have a good safety profile. Their mild nature makes them ideal for natural and organic products.
Phenoxyethanol
Phenoxyethanol is a synthetic preservative used in many cosmetics. It offers broad protection against bacteria and yeast. This preservative is often combined with other ingredients to increase effectiveness. It is less irritating than parabens and suits sensitive skin. Phenoxyethanol is stable and works well in various formulas.
Preservative Eco (geogard Ect)
Preservative Eco, also known as Geogard ECT, is an ECOCERT-approved blend. It contains benzyl alcohol, salicylic acid, glycerin, and sorbic acid. This combination gives broad-spectrum antimicrobial protection. It is popular in natural and organic skincare products. Preservative Eco is mild and well tolerated by most skin types.
Fermentation-based Preservatives
Fermentation-based preservatives come from natural microbial processes. Leucidal Liquid is a well-known example made from Lactobacillus ferment. These preservatives offer gentle protection against bacteria and fungi. They support probiotic skincare trends and natural formulations. Fermentation-based options appeal to those seeking clean beauty products.
Nature-identical Synthetics
Nature-identical synthetics are preservatives made in the lab but match natural compounds. These synthetics have the same molecular structure as substances found in plants or animals. They offer the benefit of being gentle on the skin while ensuring product safety.
Because they mimic natural molecules, these preservatives tend to cause fewer irritations. They provide reliable protection against bacteria, yeast, and mold without harsh chemicals. Many cosmetic brands prefer nature-identical synthetics for mildness and effectiveness.
What Are Nature-identical Synthetics?
Nature-identical synthetics are lab-made but chemically identical to natural preservatives. They avoid the variability of natural extracts. This consistency helps formulators create safe, stable products. They are tested for safety and skin compatibility.
Common Mild Nature-identical Synthetic Preservatives
Benzyl alcohol is a widely used nature-identical synthetic. It is gentle and provides broad antimicrobial protection. Phenoxyethanol is another popular option. It works well with other preservatives to cover a wide range of microbes.
Benefits Of Using Nature-identical Synthetics
These synthetics blend safety with strong preservation. They reduce the risk of allergic reactions. They also help maintain product freshness for longer. Their mild nature suits sensitive skin and daily-use items.
Fermentation-based Options
Fermentation-based preservatives offer a gentle approach to keeping cosmetics safe. These preservatives come from natural fermentation processes. They contain beneficial microbes or their by-products that help stop harmful bacteria and fungi from growing.
These options suit sensitive skin well. They are less likely to cause irritation than many synthetic preservatives. Their natural origin also appeals to consumers who prefer cleaner beauty products.
Leucidal Liquid
Leucidal Liquid comes from the fermentation of Lactobacillus bacteria. It fights bacteria and fungi effectively. This preservative is water-soluble and easy to use in many formulas. It also adds moisturizing benefits, supporting skin health.
Lactobacillus Ferment
Lactobacillus Ferment is a mild antimicrobial ingredient. It protects cosmetics by creating an environment that harmful microbes cannot survive in. This ferment also helps balance the skin’s natural flora, promoting overall skin comfort.
Advantages Of Fermentation-based Preservatives
These preservatives often work well with other natural ingredients. They support a product’s clean label status. They provide broad protection without harsh chemicals. Their mild nature reduces the risk of allergic reactions.
Key Formulation Factors
Choosing mild cosmetic preservatives requires understanding key formulation factors. These factors influence preservative effectiveness and product safety. They help formulators pick the best options for skin-friendly and long-lasting products.
Each cosmetic formula has unique needs. Preservatives must fit those needs without causing irritation. Knowing these factors ensures better product stability and consumer trust.
Broad-spectrum Protection
Preservatives must defend against bacteria, fungi, and yeast. Many mild preservatives work well against some microbes but not all. Combining preservatives often provides wider protection. This is crucial for preventing product spoilage and skin infections.
Ph Compatibility
Preservative effectiveness depends on product pH. Some preservatives perform best in acidic environments. Sodium Benzoate and Potassium Sorbate are effective below pH 5. Phenoxyethanol works well in a broader pH range. Matching preservative to pH prevents loss of protection.
Water Content
Preservatives need water to work properly. High water content products require stronger preservatives. Low water or anhydrous products need less or different types. Formulators consider water level to avoid overuse or underperformance of preservatives.
Ingredient Interactions
Some ingredients reduce preservative effectiveness. Oils, surfactants, and chelating agents can bind or deactivate preservatives. Testing helps identify these interactions. Adjusting preservative type or concentration ensures product safety.
Organic And Natural Standards
Products labeled organic or natural have strict preservative rules. Only certain preservatives are allowed. Mild, nature-identical synthetics or fermentation-based preservatives are preferred. Compliance guarantees product claims and consumer confidence.

Credit: www.amazon.com
Frequently Asked Questions
What Is The Safest Preservative For Cosmetics?
The safest cosmetic preservatives include Preservative Eco (Geogard ECT), Sodium Benzoate with Potassium Sorbate, and phenoxyethanol. These offer broad-spectrum protection and suit various formulations. Natural options like fermentation-based preservatives also provide gentle, effective preservation, especially for organic and sensitive products.
What Is The Most Natural Preservative?
The most natural preservative is often benzyl alcohol, found in plant oils. Fermentation-based preservatives like Leucidal Liquid also offer natural protection. These protect against bacteria and fungi while fitting organic standards and maintaining product safety.
What Is Sodium Benzoate And Potassium Sorbate In Cosmetics?
Sodium benzoate and potassium sorbate are mild preservatives in cosmetics. They prevent bacteria, yeast, and mold growth, extending product shelf life safely.
What Are The Common Cosmetic Preservatives?
Common cosmetic preservatives include phenoxyethanol, benzyl alcohol, sodium benzoate, potassium sorbate, and Geogard ECT. These protect products from bacteria, fungi, and yeast. Natural options like Leucidal Liquid (lactobacillus ferment) also offer mild, broad-spectrum preservation.
What Are Mild Cosmetic Preservatives?
Mild preservatives gently protect products from microbes without irritating skin.
Which Preservatives Are Safe For Sensitive Skin?
Phenoxyethanol, benzyl alcohol, and sodium benzoate are safe for sensitive skin.
Conclusion
Choosing mild cosmetic preservatives helps keep products safe and gentle. Options like Preservative Eco, phenoxyethanol, and sodium benzoate offer good protection. Each preservative works best in certain pH levels and formulas. Combining preservatives often improves defense against microbes. Always consider your product’s ingredients and certification needs.
Mild preservatives support skin health without harsh effects. This helps create safer, effective cosmetics for everyday use.